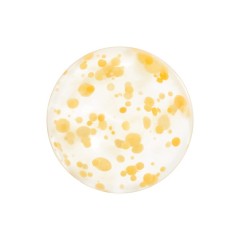
Shiseido Yuzu-C Beauty Sleeping Mask Маска для сна Yuzu-C Beauty

Поиск по запросу

Diskontshop предлагает лучшие товары и новинки бренда Shiseido. Приобретая товары в Германии, Вы можете быть уверены в оригинальном качестве продукции и надёжности доставки
Губная помада Люкс
Тени для век Люкс
Новинки косметики
Новинки средств по уходу
Подарочный набор
Средства по уходу
Крем для рук
Мужской крем для лица
Дезодоранты
12/24/36/48